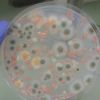

-
 +16 +1
+16 +1Newly discovered fast radio burst challenges what astronomers know about these powerful astronomical phenomena
Astronomers studying fast radio bursts recently discovered one that repeats, has a persistent radio signal and originated in a galaxy much closer than it should have.
-
 +18 +3
+18 +3New trove of data from Europe's Gaia mission will lead to best Milky Way map ever
The European Space Agency's Gaia mission will release new data on June 13, and scientists can't wait. The coming data dump will contain information about nearly two billion of the brightest objects in the sky. The release will supercharge the mapping of our Milky Way galaxy, experts say, allowing astronomers to see to the farthest fringes of the galaxy and also distinguish much finer details in its structure than ever before.
-
 +16 +3
+16 +3Scientists uncover new population of massive black holes
Traditional methods of finding black holes don't work very well in dwarf galaxies. But a group out of North Carolina has figured out a clever way to spot growing black holes in smaller galaxies.
-
 +16 +1
+16 +1Micrometeoroid knocks gold-plated mirror out of alignment on multi-billion-dollar space telescope
A tiny meteoroid struck the newly deployed James Webb Space Telescope in May, knocking one of its gold-plated mirrors out of alignment but not changing the orbiting observatory's schedule.
-
 +4 +1
+4 +1Scientists discover why Neptune and Uranus are different colours despite similarities
The difference in colour is believed to be caused by a layer of haze on both planets.
-
 +14 +1
+14 +1What is the Best Radiation Shielding for the Surface of Mars?
A new study takes a look at potential methods for radiation shielding that could inform the creation of Martian habitats
-
 +12 +2
+12 +24 hostile alien civilizations may lurk in the Milky Way, a new study suggests
But Earth is 100 times more likely to be destroyed by an asteroid than invaded by aliens.
-
 +16 +2
+16 +2China's Geely launches first nine low-orbit satellites for autonomous cars
China's Zhejiang Geely Holding Group conducted its first successful satellite launch on Wednesday, sending nine into low earth orbit as it builds out a satellite network to provide more accurate navigation for autonomous vehicles.
-
 +3 +1
+3 +1ESA conducts first tests of exoplanet hunter Plato in space-like conditions
The ESA is working on a new exoplanet hunter mission called Plato, to be launched in 2026. Astronomers expect to discover Earth-sized planets within the habitable zone thanks to Plato's ability to spot smaller planets in larger orbits than current telescopes. SRON Netherlands Institute of Space Research is contributing to the project by testing Plato's cameras in a custom built space simulator. SRON researchers have finished testing the prototype, and all features function as expected.
-
 +16 +3
+16 +3NASA chooses two companies to build spacesuits for its 21st century Moonwalkers
"We knew there was always a transition to industry in our future."
-
 +28 +2
+28 +2James Webb Space Telescope will release its 1st science-quality images July 12
It will be the day we've all been waiting for.
-
 +17 +2
+17 +2Astronomers demonstrate how using the cloud can rev up the rate of discovery for asteroids
Astronomers have used a cloud-based technique pioneered at the University of Washington to identify and track asteroids in bunches of a hundred or more. Their achievement could dramatically accelerate the quest to find potentially threatening space rocks.
-
 +17 +5
+17 +5Did NASA find Hell? Scientists brace for first glimpse of world that constantly burns
“Oceans boil away, rocks begin to melt, and the clouds rain lava.”
-
+16 +1
+16 +1Space stations could wage war on hitchhiking bacteria with self-cleaning tech
The European Space Agency is developing self-cleaning surfaces that can help get rid of bacteria and tidy up the International Space Station.
-
 +13 +2
+13 +2Ice at the moon’s poles might have come from ancient volcanoes
Volcanic eruptions billions of years ago probably released enough water vapor to have deposited ice at the lunar poles, a study finds.
-
 +15 +2
+15 +2Bricks made of dust from the Moon and Mars could make space buildings
Baking a mixture of saltwater and materials that mimic dust from the moon or Mars at a high temperature produced sturdy bricks that could be used to build human habitats in space
-
 +22 +3
+22 +3Lonestar plans to put datacenters in the Moon's lava tubes
How? Founder tells The Register 'Robots… lots of robots'
-
 +21 +4
+21 +4Over 100 years of Antarctic agriculture is helping scientists grow food in space
Scientists just grew plants in soil from the Moon, but Antarctica has long provided researchers with the perfect place to test their agricultural techniques for a future in space.
-
 +17 +1
+17 +1Pollution from SpaceX, Blue Origin, Virgin Galactic's rockets could harm human health as well as Earth's climate, study says
The study found that the concentration of nitrogen oxides released into the atmosphere was considered "hazardous to human health" under WHO standards.
-
 +4 +1
+4 +1Billionaires on the ISS Weren't Expecting to Work So Hard
The first private astronauts, who paid $55 million to journey to the ISS, needed some handholding from the regular crew.
Submit a link
Start a discussion




















